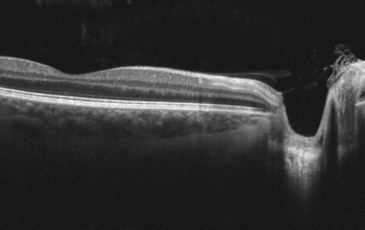

We believe that regular eye examinations should form an important part of everyone’s normal health check-ups. Not only can they detect eye conditions such as glaucoma and cataracts even before you notice the symptoms yourself, but also general health conditions such as diabetes and high blood pressure. For most people, we recommend an exam every two years or so, but we may advise you to have a more regular check if you have particular clinical needs, for example some people who have a close relative with glaucoma.
Basic NHS sight tests do not include the most modern diagnostic tools, therefore we recommend our extended eye examinations for all. Please ask our friendly staff for more information.
You can also join our Eyeplan scheme which can cover all of your professional fees and gives significant discounts on glasses and contact lenses for a modest monthly fee.
Not only do we provide routine eye examinations and contact lens assessments, but also many other specialist clinical services including dry and watery eye assessments, punctal plug fitting, blepharitis management, complex contact lens fitting, low vision care and emergency eye care.

What to expect in an eye examination
Our expert optometrists can carry out eye examinations on people of all ages. We pride ourselves on taking extra time to get to know you and work out solutions to your own personal needs.
Our eye examinations aren’t just a basic test of your sight. Your optometrist will test you for conditions like glaucoma, age-related macular degeneration (AMD) and cataracts. We recommend an enhanced eye examination for all, which includes even more time with the optometrist and scanning with the state of the art 3D optical coherence tomographer (OCT) machine. We were proud to be the first practice in the area to be able to provide this service in 2010, and the data we have from seeing patients regularly since has been invaluable in helping us detect conditions in their early stages.
Eye examinations shouldn’t be something to be worried about. That’s why our optometrists will take time to explain the procedures they are conducting, and the results. Routine eye examinations do not include anything that is painful, and we have invested in iCare tonometers, which means we can measure eye pressures without the need for the dreaded air puff!
At the end of the examination, your optometrist will have a chat with you about your results, and answer any questions you might have.
Basic eye examination
£50
NHS - no charge
Our basic private eye examination. This includes a check of your prescription and basic eye health checks.
Comprehensive eye examination
£70
NHS - just £25
This is an in-depth examination of all aspects of your vision and eye health and includes examination with the state of the art 3D OCT scanning machine. You can chose to include this in your Eyeplan scheme for just £2 a month.
Young adult eye examination
£44
For those 25 years old and under
A basic eye examination if you are 25 or under, and not eligible for NHS help towards the cost of your eye care.